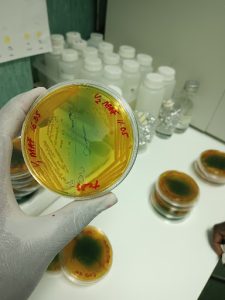

Amélia Halila Milisse (CB):
Environmental microbiology: Genomic evolution of Vibrio cholerae in the aquatic environment in areas affected by the IDAI cyclone in Moçambique.
General objective: genetic characterization of Vibrio cholerae strains circulating after cyclone Idai.
Specific objectives: To identify the presence of aquatic V. cholerae O1 in the province of Sofala in the areas affected by the cholera epidemic caused by cyclone Idai; to characterize the circulating strains of V. cholerae O1 identified after Idai; determine the relationship between clinical and environmental strains of V. cholerae O1 post Idai; determine the genetic evolution of V. cholerae O1 in the aquatic environment.
In collaboration with: DISTAV, Università di Genova, Italia